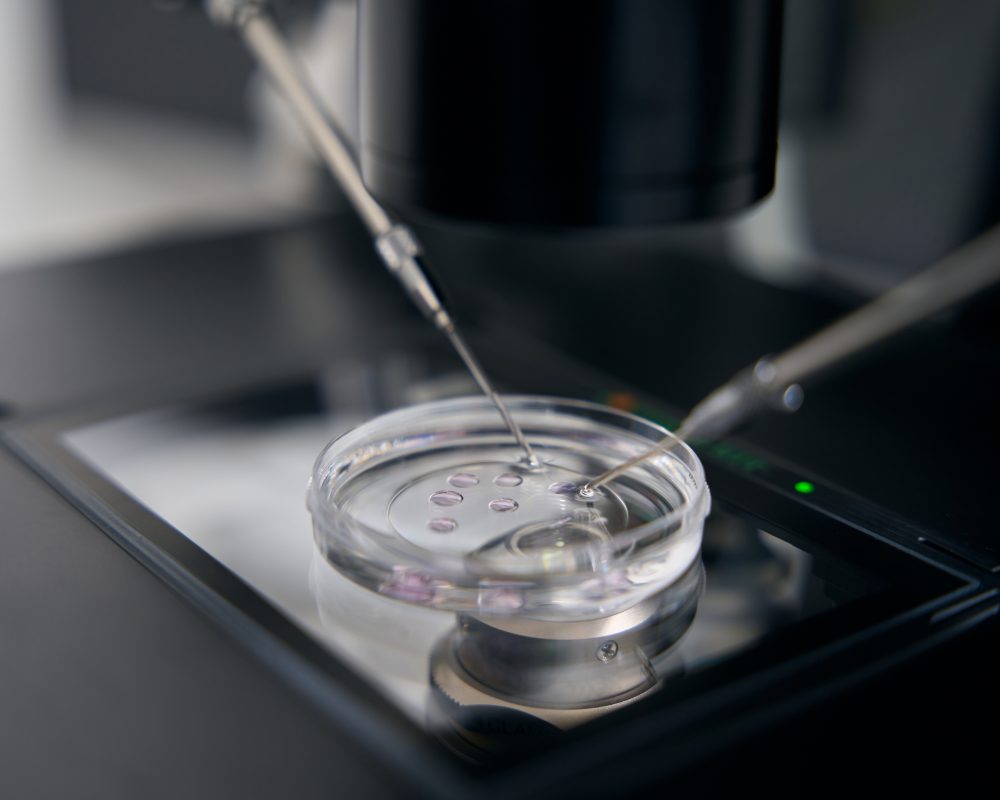

NUESTRO EQUIPO
En Laboratorios D'María, no solo somos un equipo de profesionales, somos un grupo dedicado a su bienestar.
Desde nuestro inicio, hemos forjado una sólida reputación, y nuestra pasión por lo que hacemos es palpable en cada paso que damos.


Para asegurarnos de que tu experiencia sea muy agradable, implementamos una atención a nuestros clientes impecable.
![]() Nos comprometemos a entregar resultados en tiempo y forma.
Nos comprometemos a entregar resultados en tiempo y forma.
![]() Facilitamos resultados a su médico para su correcta interpretación.
Facilitamos resultados a su médico para su correcta interpretación.
![]() Brindamos atención de calidad durante todo el proceso
Brindamos atención de calidad durante todo el proceso
![]() Contribuimos a su bienestar con resultados confiables.
Contribuimos a su bienestar con resultados confiables.